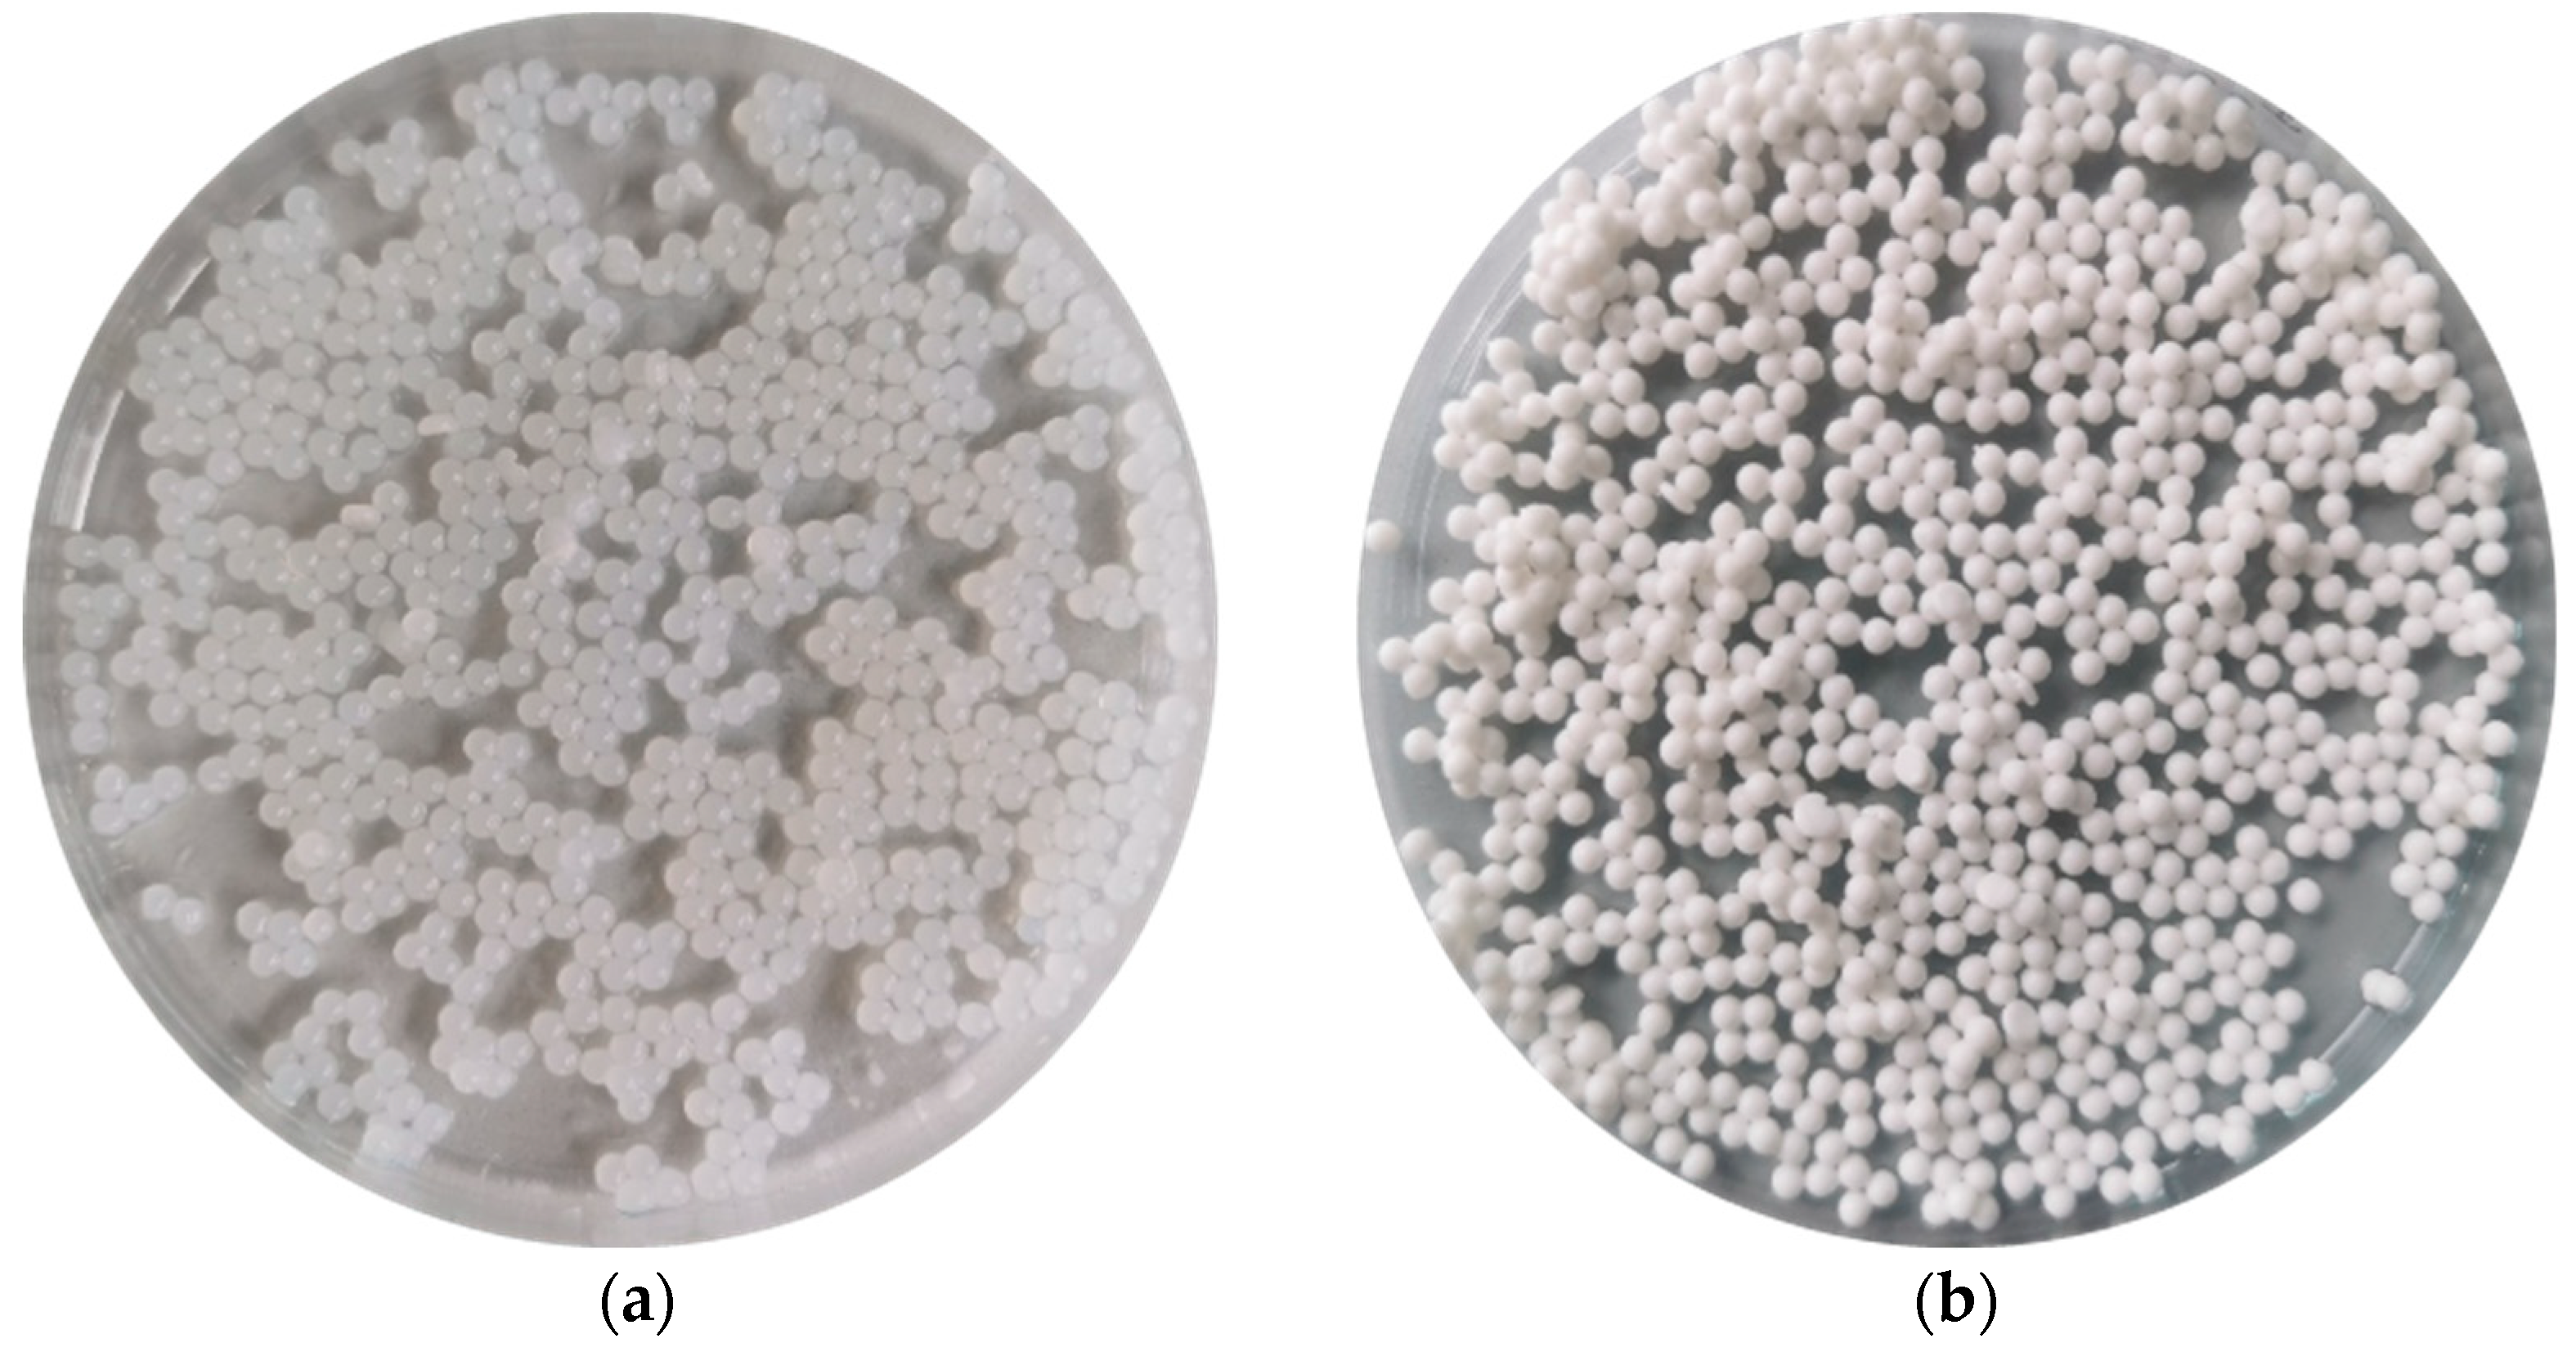

Zinc Acetate as a Cross-Linking Agent in the Development of Enteric Microcapsules for Posaconazole
Abstract
1. Introduction
2. Materials and Methods
2.1. Development of ALG and ALG/PEC Microcapsules
2.2. Attributies of ALG and ALG/PEC Dilutions
2.3. Microcapsules Quality Assessment
2.3.1. Scanning Electron Microscopy (SEM)
2.3.2. Microcapsules Weight and Diameter Uniformity
2.3.3. Homogeneity of Active Substance Ingredient, Encapsulation Efficiency, and Production Yield
2.3.4. Swelling Ability
2.3.5. Firmness and Mucoadhesiveness
2.3.6. Posaconazole In Vitro Release Evaluation
2.3.7. Antifungal Activity Evaluation
2.3.8. Perform a Thermal Analysis
2.3.9. Attenuated Total Reflectance–Fourier Transform Infrared Spectroscopy (ATR–FTIR)
2.4. Statistical Analysis
3. Results
3.1. Quality Estimation of ALG and ALG/PEC Microcapsules
3.2. Swelling and Mucoadhesiveness
3.3. In Vitro POS Release
3.4. Antifungal Activity
3.5. Thermal Analysis
3.6. Attenuated Total Reflectance–Fourier Transform Infrared Spectroscopy (ATR–FTIR)
4. Conclusions
Author Contributions
Funding
Institutional Review Board Statement
Informed Consent Statement
Data Availability Statement
Acknowledgments
Conflicts of Interest
References
- Al-Hashimi, N.; Begg, N.; Alany, R.G.; Hassanin, H.; Elshaer, A. Oral modified release multiple-unit particulate systems: Compressed pellets, microparticles and nanoparticles. Pharmaceutics 2018, 10, 176. [Google Scholar] [CrossRef]
- Uhumwangho, M.U.; Okor, R.S. Multi-unit dosage formulations of theophylline for controlled release application. Acta Pol. Pharm. 2007, 64, 553–559. [Google Scholar]
- Bah, M.G.; Bilal, H.M.; Wang, J. Fabrication and application of complex microcapsules: A review. Soft Matter 2020, 16, 570–590. [Google Scholar] [CrossRef]
- Leung, S.; Poulakos, M.; Machin, J. Posaconazole: An update of its clinical use. Pharmacy 2015, 3, 210–268. [Google Scholar] [CrossRef] [PubMed]
- Tang, P. Determination of posaconazole in plasma/serum by high-performance liquid chromatography with fluorescence detection. Separations 2017, 4, 16. [Google Scholar] [CrossRef]
- McKeage, K. Posaconazole: A review of the gastro-resistant tablet and intravenous solution in invasive fungal infections. Drugs 2015, 75, 397–406. [Google Scholar] [CrossRef] [PubMed]
- Szekalska, M.; Puciłowska, A.; Szymańska, E.; Ciosek, P.; Winnicka, K. Alginate: Current use and future perspectives in pharmaceutical and biomedical applications. Int. J. Polym. Sci. 2016, 2016, 7697031. [Google Scholar] [CrossRef]
- Hariyadi, D.M.; Islam, N. Current status of alginate in drug delivery. Adv. Pharmacol. Pharm. Sci. 2020, 2020, 8886095. [Google Scholar] [CrossRef] [PubMed]
- Tan, L.L.; Mahotra, M.; Chan, S.Y.; Loo, S.C.J. In situ alginate crosslinking during spray-drying of Lactobacilli probiotics promotes gastrointestinal-targeted delivery. Carbohydr. Polym. 2022, 286, 119279. [Google Scholar] [CrossRef] [PubMed]
- Belščak-Cvitanović, A.; Jurić, S.; Đorđević, V.; Barišić, L.; Komes, D.; Ježek, D.; Bugarski, B.; Nedović, V. Chemometric evaluation of binary mixtures of alginate and polysaccharide biopolymers as carriers for microencapsulation of green tea polyphenols. Int. J. Food Prop. 2017, 20, 1971–1986. [Google Scholar] [CrossRef]
- Walkenström, P.; Kidman, S.; Hermansson, A.-M.; Rasmussen, P.B.; Hoegh, L. Microstructure and rheological behaviour of alginate/pectin mixed gels. Food Hydrocoll. 2003, 17, 593–603. [Google Scholar] [CrossRef]
- Vallejo-Castillo, V.; Rodríguez-Stouvenel, A.; Martínez, R.; Bernal, C. Development of alginate-pectin microcapsules by the extrusion for encapsulation and controlled release of polyphenols from Papaya (Carica papaya L.). J. Food Biochem. 2020, 44, e13331. [Google Scholar] [CrossRef] [PubMed]
- Deepathomas, D.; Latha, M.S.; Kurienthomas, K. Zinc alginate beads for the controlled release of rifampicin. Orient. J. Chem. 2018, 34, 428–433. [Google Scholar] [CrossRef]
- Xie, J.; Zhu, L.; Zhu, T.; Jian, Y.; Ding, Y.; Zhou, M.; Feng, X. Zinc supplementation reduces Candida infections in pediatric intensive care unit: A randomized placebo-controlled clinical trial. J. Clin. Biochem. Nutr. 2019, 64, 170–173. [Google Scholar] [CrossRef]
- Szekalska, M.; Wróblewska, M.; Czajkowska-Kośnik, A.; Sosnowska, K.; Misiak, P.; Wilczewska, A.Z.; Winnicka, K. The spray-dried alginate/gelatin microparticles with luliconazole as mucoadhesive drug delivery system. Materials 2023, 16, 403. [Google Scholar] [CrossRef] [PubMed]
- Szekalska, M.; Czajkowska-Kośnik, A.; Maciejewski, B.; Misztalewska-Turkowicz, I.; Wilczewska, A.Z.; Bernatoniene, J.; Winnicka, K. Mucoadhesive alginate/pectin films crosslinked by calcium carbonate as carriers of a model antifungal drug—Posaconazole. Pharmaceutics 2023, 15, 2415. [Google Scholar] [CrossRef] [PubMed]
- Hagesaether, E.; Bye, R.; Sande, S.A. Ex vivo mucoadhesion of different zinc-pectinate hydrogel beads. Int. J. Pharm. 2008, 347, 9–15. [Google Scholar] [CrossRef] [PubMed]
- Council of Europe. The European Pharmacopeia, 9th ed.; Council of Europe: Strasburg, France, 2016; Volume 1, p. 302. [Google Scholar]
- Costa, P.; Sousa Lobo, J.M. Modeling and comparison of dissolution profiles. Eur. J. Pharm. Sci. 2001, 13, 123–133. [Google Scholar] [CrossRef]
- Rex, J.H. Reference Method for Broth Dilution Antifungal Susceptibility Testing of Yeasts, 3rd ed.; CLSI DocumentM27-A3; Clinical & Laboratory Standards Institute: Wayne, PA, USA, 2008. [Google Scholar]
- Chan, L.W.; Jin, Y.; Heng, P.W.S. Cross-Linking mechanisms of calcium and zinc in production of alginate microspheres. Int. J. Pharm. 2002, 242, 255–258. [Google Scholar] [CrossRef] [PubMed]
- Kotagale, N.; Raut, N.; Umekar, M.; Deshmukh, P. Zinc cross-linked hydroxamated alginates for pulsed drug release. Int. J. Pharm. Investig. 2013, 3, 194. [Google Scholar] [CrossRef] [PubMed]
- Auriemma, G.; Mencherini, T.; Russo, P.; Stigliani, M.; Aquino, R.P.; Del Gaudio, P. Prilling for the development of multi-particulate colon drug delivery systems: Pectin vs. pectin–alginate beads. Carbohydr. Polym. 2013, 92, 367–373. [Google Scholar] [CrossRef] [PubMed]
- Hamouda, R.A.; Alharbi, A.A.; Al-Tuwaijri, M.M.; Makharita, R.R. The antibacterial activities and characterizations of biosynthesized zinc oxide nanoparticles, and their coated with alginate derived from Fucus vesiculosus. Polymers 2023, 15, 2335. [Google Scholar] [CrossRef] [PubMed]
- Nayak, A.K.; Das, B.; Maji, R. Calcium alginate/gum arabic beads containing glibenclamide: Development and in vitro characterization. Int. J. Biol. Macromol. 2012, 51, 1070–1078. [Google Scholar] [CrossRef]
- Veronica, N.; Heng, P.W.S.; Liew, C.V. Relative humidity cycling: Implications on the stability of moisture-sensitive drugs in solid pharmaceutical products. Mol. Pharm. 2023, 20, 1072–1085. [Google Scholar] [CrossRef]
- Matulyte, I.; Kasparaviciene, G.; Bernatoniene, J. Development of new formula microcapsules from nutmeg essential oil using sucrose esters and magnesium aluminometasilicate. Pharmaceutics 2020, 12, 628. [Google Scholar] [CrossRef] [PubMed]
- Carbinatto, F.M.; De Castro, A.D.; Evangelista, R.C.; Cury, B.S.F. Insights into the swelling process and drug release mechanisms from cross-linked pectin/high amylose starch matrices. Asian J. Pharm. Sci. 2014, 9, 27–34. [Google Scholar] [CrossRef]
- Bartkowiak, A.; Rojewska, M.; Hyla, K.; Zembrzuska, J.; Prochaska, K. Surface and swelling properties of mucoadhesive blends and their ability to release fluconazole in a mucin environment. Colloids Surf. B Biointerfaces 2018, 172, 586–593. [Google Scholar] [CrossRef] [PubMed]
- Sharma, R.; Bajpai, J.; Bajpai, A.K.; Acharya, S.; Shrivastava, R.B.; Shukla, S.K. Designing slow water-releasing alginate nanoreserviors for sustained irrigation in scanty rainfall areas. Carbohydr. Polym. 2014, 102, 513–520. [Google Scholar] [CrossRef] [PubMed]
- Peretiatko, C.D.S.; Hupalo, E.A.; Campos, J.R. da R.; Parabocz, C.R.B. Efficiency of zinc and calcium ion crosslinking in alginate-coated nitrogen fertilizer. Orbital Electron. J. Chem. 2018, 10, 218–225. [Google Scholar] [CrossRef]
- Sharma, R.; Kumar, S.; Malviya, R.; Prajapati, B.G.; Puri, D.; Limmatvapirat, S.; Sriamornsak, P. Recent advances in biopolymer-based mucoadhesive drug delivery systems for oral application. J. Drug Deliv. Sci. Technol. 2024, 91, 105227. [Google Scholar] [CrossRef]
- Sriamornsak, P.; Wattanakorn, N.; Takeuchi, H. Study on the mucoadhesion mechanism of pectin by atomic force microscopy and mucin-particle method. Carbohydr. Polym. 2010, 79, 54–59. [Google Scholar] [CrossRef]
- Awasthi, R.; Kulkarni, G.T.; Ramana, M.V.; De Jesus Andreoli Pinto, T.; Kikuchi, I.S.; Molim Ghisleni, D.D.; De Souza Braga, M.; De Bank, P.; Dua, K. Dual crosslinked pectin–alginate network as sustained release hydrophilic matrix for repaglinide. Int. J. Biol. Macromol. 2017, 97, 721–732. [Google Scholar] [CrossRef] [PubMed]
- Pawar, V.K.; Kansal, S.; Garg, G.; Awasthi, R.; Singodia, D.; Kulkarni, G.T. Gastroretentive dosage forms: A review with special emphasis on floating drug delivery systems. Drug Deliv. 2011, 18, 97–110. [Google Scholar] [CrossRef]
- Boddupalli, B.M.; Mohammed, Z.N.K.; Nath, R.A.; Banji, D. Mucoadhesive drug delivery system: An overview. J. Adv. Pharm. Technol. Res. 2010, 1, 381. [Google Scholar] [CrossRef] [PubMed]
- Jelvehgari, M.; Mobaraki, V.; Montazam, S.H. Preparation and valuation of mucoadhesive beads/discs of alginate and algino-pectinate of piroxicam for colon-specific drug delivery via oral route. Jundishapur J. Nat. Pharm. Prod. 2014, 9, e16576. [Google Scholar] [CrossRef] [PubMed]
- Kim, Y.; Park, E.J.; Kim, T.W.; Na, D.H. Recent progress in drug release testing methods of biopolymeric particulate system. Pharmaceutics 2021, 13, 1313. [Google Scholar] [CrossRef]
- Caballero, F.; Foradada, M.; Miñarro, M.; Pérez-Lozano, P.; García-Montoya, E.; Ticó, J.R.; Suñé-Negre, J.M. Characterization of alginate beads loaded with ibuprofen lysine salt and optimization of the preparation method. Int. J. Pharm. 2014, 460, 181–188. [Google Scholar] [CrossRef] [PubMed]
- Auriemma, G.; Cerciello, A.; Aquino, R.P.; Del Gaudio, P.; Fusco, B.M.; Russo, P. Pectin and zinc alginate: The right inner/outer polymer combination for core-shell drug delivery systems. Pharmaceutics 2020, 12, 87. [Google Scholar] [CrossRef] [PubMed]
- Strobel, S.A.; Scher, H.B.; Nitin, N.; Jeoh, T. In situ cross-linking of alginate during spray-drying to microencapsulate lipids in powder. Food Hydrocoll. 2016, 58, 141–149. [Google Scholar] [CrossRef]
- Solanki, D.; Motiwale, M. Studies on drug release kinetics and mechanism from sustained release matrix tablets of isoniazid using natural polymer obtained from Dioscorea alata. Int. J. ChemTech Res. 2020, 13, 166–173. [Google Scholar] [CrossRef]
- Mankala, S.; Korla, A.; Gade, S. Development and evaluation of aceclofenac-loaded mucoadhesive microcapsules. J. Adv. Pharm. Technol. Res. 2011, 2, 245. [Google Scholar] [CrossRef]
- Zhang, Z.; Bills, G.F.; An, Z. Advances in the treatment of invasive fungal disease. PLOS Pathog. 2023, 19, e1011322. [Google Scholar] [CrossRef]
- Ciriminna, R.; Fidalgo, A.; Meneguzzo, F.; Presentato, A.; Scurria, A.; Nuzzo, D.; Alduina, R.; Ilharco, L.M.; Pagliaro, M. Pectin: A long-neglected broad-spectrum antibacterial. ChemMedChem 2020, 15, 2228–2235. [Google Scholar] [CrossRef] [PubMed]
- Gong, Y.; Han, G.; Zhang, Y.; Pan, Y.; Li, X.; Xia, Y.; Wu, Y. Antifungal activity and cytotoxicity of zinc, calcium, or copper alginate fibers. Biol. Trace Elem. Res. 2012, 148, 415–419. [Google Scholar] [CrossRef]
- Lakshmanan, A.; Govindasamy, C.; Sivakumar, A.S.; Hussein-Al-Ali, S.H.; Ramesh, M.; Lakshmanan, H. Anticancer and antimicrobial potential of zinc/sodium alginate/polyethylene glycol/d-pinitol nanocomposites against osteosarcoma MG-63 cells. Green Process. Synth. 2023, 12, 20230124. [Google Scholar] [CrossRef]
- Pasquet, J.; Chevalier, Y.; Pelletier, J.; Couval, E.; Bouvier, D.; Bolzinger, M.-A. The contribution of zinc ions to the antimicrobial activity of zinc oxide. Colloids Surf. Physicochem. Eng. Asp. 2014, 457, 263–274. [Google Scholar] [CrossRef]
- Felix, C.B.; Chen, W.-H.; Ubando, A.T.; Park, Y.-K.; Lin, K.-Y.A.; Pugazhendhi, A.; Nguyen, T.-B.; Dong, C.-D. Comprehensive review of thermogravimetric analysis in lignocellulosic and algal biomass gasification. Chem. Eng. J. 2022, 445, 136730. [Google Scholar] [CrossRef]
- Flores-Hernández, C.G.; Cornejo-Villegas, M.D.L.A.; Moreno-Martell, A.; Del Real, A. Synthesis of a biodegradable polymer of poly (sodium alginate/ethyl acrylate). Polymers 2021, 13, 504. [Google Scholar] [CrossRef] [PubMed]
- Ruano, P.; Lazo Delgado, L.; Picco, S.; Villegas, L.; Tonelli, F.; Eduardo Aguilera Merlo, M.; Rigau, J.; Diaz, D.; Masuelli, M. Extraction and characterization of pectins from peels of criolla oranges (Citrus sinensis): Experimental reviews. In Pectins—Extraction, Purification, Characterization and Applications; Masuelli, M., Ed.; IntechOpen: London, UK, 2020. [Google Scholar] [CrossRef]
- Kozioł, A.; Środa-Pomianek, K.; Górniak, A.; Wikiera, A.; Cyprych, K.; Malik, M. Structural determination of pectins by spectroscopy methods. Coatings 2022, 12, 546. [Google Scholar] [CrossRef]
- Sánchez-Fernández, J.A.; Presbítero-Espinosa, G.; Peña-Parás, L.; Pizaña, E.I.R.; Galván, K.P.V.; Vopálenský, M.; Kumpová, I.; Elizalde-Herrera, L.E. Characterization of sodium alginate hydrogels reinforced with nanoparticles of hydroxyapatite for biomedical applications. Polymers 2021, 13, 2927. [Google Scholar] [CrossRef] [PubMed]
- Akinalan Balik, B.; Argin, S.; Lagaron, J.M.; Torres-Giner, S. Preparation and characterization of electrospun pectin-based films and their application in sustainable aroma barrier multilayer packaging. Appl. Sci. 2019, 9, 5136. [Google Scholar] [CrossRef]
- Pandav, T.; Devare, T.; Pant, P.; Devare, T.; Mali, A. Dr development of posaconazole delayed release formulation for mucormycosis by hot melt extrusion using qbd approach. J. Adv. Sci. Res. 2023, 14, 28–39. [Google Scholar] [CrossRef]
- Gurunath, S.; Pradeep Kumar, S.; Basavaraj, N.K.; Patil, P.A. Amorphous solid dispersion method for improving oral bioavailability of poorly water-soluble drugs. J. Pharm. Res. 2013, 6, 476–480. [Google Scholar] [CrossRef]
- Måge, I.; Böcker, U.; Wubshet, S.G.; Lindberg, D.; Afseth, N.K. Fourier-transform infrared (FTIR) fingerprinting for quality assessment of protein hydrolysates. LWT 2021, 152, 112339. [Google Scholar] [CrossRef]

| Formulation | ALG [%] | PEC [%] | POS [%] | Zn2+ [%] | Polysorbate 80 [%] |
|---|---|---|---|---|---|
| P1 | 2 | – | – | 2 | 1 |
| P2 | 2 | – | – | 3 | 1 |
| P3 | 2 | – | – | 5 | 1 |
| P4 | 1 | 1 | – | 2 | 1 |
| P5 | 1 | 1 | – | 3 | 1 |
| P6 | 1 | 1 | – | 5 | 1 |
| F1 | 2 | – | 5 | 2 | 1 |
| F2 | 2 | – | 5 | 3 | 1 |
| F3 | 2 | – | 5 | 5 | 1 |
| F4 | 1 | 1 | 5 | 2 | 1 |
| F5 | 1 | 1 | 5 | 3 | 1 |
| F6 | 1 | 1 | 5 | 5 | 1 |
| pH | Viscosity (mPa∙s) | |
|---|---|---|
| 2% ALG | 8.02 ± 0.02 | 2413.33 ± 40.41 |
| 2% ALG/5% POS | 7.60 ± 0.06 | 233.33 ± 20.82 * |
| 1% ALG/1% PEC | 4.92 ± 0.09 * | 343.33 ± 5.77 * |
| 1% ALG/1% PEC/5% POS | 4.73 ± 0.05 * | 287.0 ± 6.08 * |
| Formulation | Diameter (mm) | Production Yield (%) | Drug Loading (%) | Encapsulation Efficiency (%) | |
|---|---|---|---|---|---|
| Wet | Dry | ||||
| P1 | 2.85 ± 0.26 | 1.24 ± 0.03 | 90.04 ± 4.66 * | – | – |
| P2 | 3.12 ± 0.21 | 1.15 ± 0.05 * | 98.13 ±1.80 * | – | – |
| P3 | 3.35 ± 0.16 | 1.00 ± 0.05 ** | 75.64 ± 3.57 * | – | – |
| P4 | 3.16 ± 0.10 | 1.15 ± 0.02 * | 68.33 ± 8.13 * | – | – |
| P5 | 3.09 ± 0.08 | 1.07 ± 0.03 ** | 58.47 ± 1.27 * | – | – |
| P6 | 3.09 ± 0.18 | 0.94 ± 0.03 ** | 57.31 ± 0.86 * | – | – |
| F1 | 3.09 ± 0.08 | 1.50 ± 0.02 | 39.54 ± 1.12 | 73.81 ± 3.68 | 103.35 ± 5.15 |
| F2 | 2.99 ± 0.07 | 1.48 ± 0.04 | 40.12 ± 0.60 | 74.24 ± 4.19 | 103.95 ± 5.87 |
| F3 | 3.02 ± 0.13 | 1.48 ± 0.02 | 38.38 ± 1.10 | 69.04 ± 6.48 * | 96.67 ± 9.07 * |
| F4 | 3.03 ± 0.08 | 1.24 ± 0.04 | 39.13 ± 0.48 | 82.07 ± 4.98 * | 114.92 ± 6.97 * |
| F5 | 2.97 ± 0.08 | 1.21 ± 0.04 | 34.12 ± 0.48 * | 79.26 ± 2.21 | 110.98 ± 3.10 |
| F6 | 2.88 ± 0.05 * | 1.18 ± 0.06 ** | 33.92 ± 0.40 * | 71.17 ± 1.48 | 99.65 ± 2.08 |
| Formulation | Zero-Order Kinetics | First-Order Kinetics | Highuchi Model | Hixson–Crowell Model | Korsmeyer–Peppas Model | ||||||
|---|---|---|---|---|---|---|---|---|---|---|---|
| R2 | K | R2 | K | R2 | K | R2 | K | R2 | K | n | |
| F1 | 0.78 | 0.56 | 0.84 | 0.02 | 0.73 | 10.61 | 0.71 | 0.02 | 0.81 | 1.20 | 1.70 |
| F2 | 0.78 | 0.55 | 0.84 | 0.02 | 0.74 | 10.50 | 0.71 | 0.02 | 0.82 | 1.29 | 1.75 |
| F3 | 0.78 | 0.55 | 0.85 | 0.02 | 0.76 | 10.47 | 0.72 | 0.02 | 0.82 | 1.29 | 2.17 |
| F4 | 0.79 | 0.56 | 0.85 | 0.02 | 0.75 | 10.60 | 0.72 | 0.02 | 0.82 | 1.30 | 1.91 |
| F5 | 0.79 | 0.56 | 0.85 | 0.02 | 0.75 | 10.58 | 0.72 | 0.02 | 0.82 | 1.30 | 1.96 |
| F6 | 0.79 | 0.56 | 0.84 | 0.02 | 0.74 | 10.58 | 0.98 | 0.03 | 0.82 | 1.30 | 1.99 |
Disclaimer/Publisher’s Note: The statements, opinions and data contained in all publications are solely those of the individual author(s) and contributor(s) and not of MDPI and/or the editor(s). MDPI and/or the editor(s) disclaim responsibility for any injury to people or property resulting from any ideas, methods, instructions or products referred to in the content. |
© 2025 by the authors. Licensee MDPI, Basel, Switzerland. This article is an open access article distributed under the terms and conditions of the Creative Commons Attribution (CC BY) license (https://creativecommons.org/licenses/by/4.0/).
Share and Cite
Szekalska, M.; Kasparavičienė, G.; Bernatonienė, J.; Wolska, E.; Misiak, P.; Markiewicz, K.H.; Wilczewska, A.Z.; Czajkowska-Kośnik, A.; Winnicka, K. Zinc Acetate as a Cross-Linking Agent in the Development of Enteric Microcapsules for Posaconazole. Pharmaceutics 2025, 17, 291. https://doi.org/10.3390/pharmaceutics17030291
Szekalska M, Kasparavičienė G, Bernatonienė J, Wolska E, Misiak P, Markiewicz KH, Wilczewska AZ, Czajkowska-Kośnik A, Winnicka K. Zinc Acetate as a Cross-Linking Agent in the Development of Enteric Microcapsules for Posaconazole. Pharmaceutics. 2025; 17(3):291. https://doi.org/10.3390/pharmaceutics17030291
Chicago/Turabian StyleSzekalska, Marta, Giedrė Kasparavičienė, Jurga Bernatonienė, Eliza Wolska, Paweł Misiak, Karolina Halina Markiewicz, Agnieszka Zofia Wilczewska, Anna Czajkowska-Kośnik, and Katarzyna Winnicka. 2025. "Zinc Acetate as a Cross-Linking Agent in the Development of Enteric Microcapsules for Posaconazole" Pharmaceutics 17, no. 3: 291. https://doi.org/10.3390/pharmaceutics17030291
APA StyleSzekalska, M., Kasparavičienė, G., Bernatonienė, J., Wolska, E., Misiak, P., Markiewicz, K. H., Wilczewska, A. Z., Czajkowska-Kośnik, A., & Winnicka, K. (2025). Zinc Acetate as a Cross-Linking Agent in the Development of Enteric Microcapsules for Posaconazole. Pharmaceutics, 17(3), 291. https://doi.org/10.3390/pharmaceutics17030291

